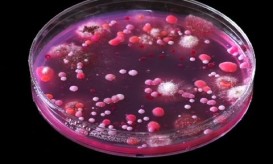

Την πυροβόλησαν στο πρόσωπο και οι γιατροί της μεταμόσχευσαν νέο- VIDEO
Το να πούμε πλέον, ότι η “επιστήμη κάνει θαύματα”, δεν είναι υπερβολή. Μια γυναίκα από τις ΗΠΑ, που δέχτηκε...

Το να πούμε πλέον, ότι η “επιστήμη κάνει θαύματα”, δεν είναι υπερβολή. Μια γυναίκα από τις ΗΠΑ, που δέχτηκε...

Και εάν αναρωτιέστε πως ένα σουτιέν μπορεί να σώζει ζωές, σας λέμε ότι ναι πράγματι μπορεί. Πρόκειται ουσιαστικά για...

Έχετε αναρωτηθεί ποτέ πως λειτουργεί η σπερματέγχυση και πως εάν τελικά πετύχει θα αυξήσει τις πιθανότητες τουλάχιστον μέχρι και...
Αλήθεια έχετε αναρωτηθεί ποτέ, ποιες είναι οι πλέον θανατηφόρες ασθένειες στον κόσμο; Από τι πεθαίνουν ακόμη οι άνθρωποι σε...

Στο βίντεο που θα δείτε θα μπορέσετε να κατανοήσετε με τη βοήθεια της τεχνολογίας, πως ενεργοποιείται και πως λειτουργεί...

Οι εικόνες του βίντεο που θα δείτε είναι μια πραγματικότητα, όσο και να σοκάρει και όσο και αποκρουστική και...

Το βίντεο που θα παρακολουθήσετε είναι μια πραγματικότητα. Στη Μοζαμβίκη, όταν κάποιος έχει πονοκεφάλους και δεν ζει σε κάποια...

Στο βίντεο που θα παρακολουθήσετε θα δείτε φωτογραφίες θυμάτων της φυματίωσης. Η φυματίωση, μια αρχαία ασθένεια που σχεδόν είχε...

Η Λίζι Βελάσκες, είναι ένα 23 ετών κορίτσι από το Ώστιν του Τέξας. Όποιος την βλέπει για πρώτη φορά...

Η μικρή Αγγλιδούλα λέγεται Zara Hartshorn και πάσχει από μια σπάνια ασθένεια. Μόλις μπαίνει στην εφηβεία, στο πρόσωπο όμως...

Σήμερα είναι 78 χρονών και ζει σε ένα χωριό στο Περού, ψηλά στις Άνδεις. Αποφεύγει να μιλήσει στους δημοσιογράφους...

Και όμως αυτά είναι τα λόγια διαφημιστικού, που αυτή τη στιγμή στην Ινδία, προβάλλεται σε τηλεοράσεις, και ακούγεται στα...

Ακόμη και θεραπευτικές ιδιότητες φαίνεται πως έχουν τα ζώα συντροφιάς. Εκτός από χαρά και ευχάριστη παρέα, οι επιστήμονες αποδεικνύουν...

Σε αυτό το απίστευτο βίντεο θα μάθετε 10 πράγματα για την εγκεφαλική λειτουργία τα οποία οι περισσότεροι αγνοούν. Για...

Είναι από τις στιγμές που νιώθεις τη γη να φεύγει κάτω από τα πόδια σου. Το να χάσεις το...